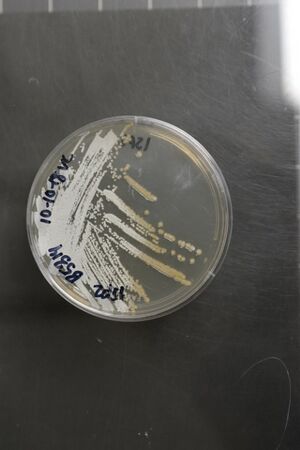

Streptomyces natalensis الإنجليزية (Q2998094)
نوع من بدائيات النوى
| اللغة | التسمية | الوصف | أسماء أخرى |
|---|---|---|---|
| العربية | لم تُضف التسمية |
نوع من بدائيات النوى |
|
| الإنجليزية | Streptomyces natalensis |
species of bacterium |
بيانات
Wikidata item الإنجليزية
taxon name الإنجليزية
taxon rank الإنجليزية
parent taxon الإنجليزية
instance of الإنجليزية
Gram staining الإنجليزية
Microsoft Academic ID الإنجليزية
Freebase ID الإنجليزية
image الإنجليزية
Streptomyces natalensis NRRL B-5314 (Type Strain).jpg
٤٨٠ × ٧٢٠؛ ١٠٥ كيلوبايت
٤٨٠ × ٧٢٠؛ ١٠٥ كيلوبايت
١ مراجع
Imported from Wikidata item الإنجليزية
short name الإنجليزية